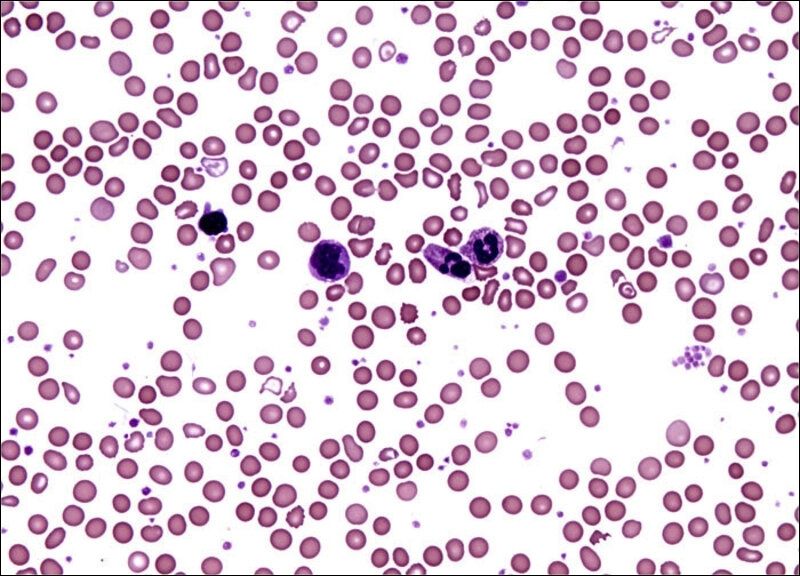

Vitamin B12 là thành phần dinh dưỡng quen thuộc trong các bữa ăn và thực phẩm chức năng bổ sung hàng ngày. Vậy vitamin B12 có tác dụng gì và nên uống lúc nào là tốt nhất? Cùng Docosan giải đáp thắc mắc qua bài viết dưới đây.
Tóm tắt nội dung
- 1 Giới thiệu tổng quát về Vitamin B12
- 2 Vitamin B12 có tác dụng gì? 9 công dụng nổi bật
- 3 Nguyên nhân gây thiếu hụt Vitamin B12
- 4 Dấu hiệu cơ thể thiếu hụt Vitamin B12
- 5 Những đối tượng có nguy cơ thiếu hụt Vitamin B12
- 6 Một số tác dụng phụ của Vitamin B12
- 7 Cách bổ sung Vitamin B12 hiệu quả
- 8 Cách dùng, liều dùng và một số tương tác thuốc khi bổ sung Vitamin B12
- 9 Đối tượng không nên bổ sung Vitamin B12
- 10 Một số lưu ý khi bổ sung Vitamin B12 hiệu quả
- 11 Khi nào cần gặp bác sĩ?
- 12 Một số câu hỏi liên quan
Giới thiệu tổng quát về Vitamin B12
Vitamin B12 (Cyanocobalamin) là gì?
Vitamin B12, còn được gọi là Cyanocobalamin, là một dạng vitamin B có trong thực phẩm. Vitamin B12 rất quan trọng cho sự tăng trưởng, sinh sản tế bào và năng lượng trong cơ thể con người, đặc biệt là đảm bảo hình thành tế bào hồng cầu và bảo vệ tế bào thần kinh khỏe mạnh.
Vitamin B12 được hấp thu vào cơ thể nhờ sự hỗ trợ của các yếu tố nội tại. Cấu trúc của vitamin này gồm một nguyên tử Cobalt ở trung tâm và một vòng Corrin bao quanh bên ngoài. Khác với các vitamin nhóm B khác, vitamin B12 không được tổng hợp bởi động vật, nấm hoặc thực vật. Vitamin này chỉ được tổng hợp chủ yếu từ vi khuẩn kị khí hoặc cổ khuẩn trong điều kiện có Cobalt và thường tìm thấy ở dạng hoạt động tự nhiên là Adenosylcobalamin (hay còn gọi là Coenzyme B12) và Methylcobalamin.
Mặc dù, hệ vi khuẩn đường ruột của con người có thể tổng hợp vitamin B12, tuy nhiên con người không thể hấp thụ và sử dụng được. Vì vậy, vitamin này được hấp thu thông qua thức ăn.
Quá trình hấp thu vitamin B12 của cơ thể bao gồm:
- Vitamin B12 trong thực phẩm liên kết với protein và được phân tách trong môi trường acid của dạ dày với sự hỗ trợ của pepsin.
- Tế bào thành dạ dày sản xuất yếu tố nội tại. Các protease tuyến tụy tiết vào tá tràng giải phóng vitamin này dưới dạng tự do, cho phép vitamin B12 liên kết với yếu tố nội tại.
- Phức hợp yếu tố nội tại và vitamin B12 được hấp thụ bởi các thụ thể niêm mạc ở hồi tràng và sau đó được hấp thu vào máu và thực hiện các chuyển hoá cần thiết cho cơ thể.

Vai trò của B12 đối với cơ thể
Vitamin B12 đóng vai trò thiết yếu trong quá trình hình thành tế bào hồng cầu, tham gia vào quá trình chuyển hóa tế bào, bảo vệ chức năng hệ thần kinh trung ương (bao gồm não và tủy sống) và làm nhiệm vụ sản xuất DNA, RNA, các phân tử bên trong tế bào mang thông tin di truyền. Bên cạnh đó, vitamin B12 còn giúp giữ cho tóc, móng và da của con người khỏe mạnh. Cụ thể:
- Tổng hợp DNA và RNA: Vitamin B12 và Folat đóng vai trò quan trọng sự tổng hợp DNA và RNA. Vitamin B12 là một trong những thành phần quan trọng trong phản ứng tạo thành Tetrahydrofolate và Methionine, các thành phần cần thiết cho quá trình phân chia và trưởng thành của tế bào trong cơ thể.
- Quá trình tạo máu: Vitamin B12 đóng vai trò quan trọng trong quá trình sản xuất các tế bào hồng cầu. Việc thiếu vitamin này ảnh hưởng đến quá trình tổng hợp DNA và RNA liên quan đến quá trình tạo hồng cầu dẫn. Trong trường hợp này, các hồng cầu được tạo thành có kích thước lớn hơn bình thường và không thể thực hiện các chức năng sinh hoá của cơ thể.
- Chức năng thần kinh: Vitamin B12 là thành phần quan trọng trong quá trình tổng hợp bao myelin. Myelin là một chất giàu lipid bao quanh sợi trục của một số tế bào thần kinh, tạo thành một lớp cách điện giúp hệ thần kinh hoạt động một cách chính xác.

B12 được tìm thấy ở đâu?
Cơ thể không tự tạo ra vitamin B12, vì vậy con người cần phải lấy chúng từ những thực phẩm có nguồn gốc động vật như gia cầm, thịt, cá và các sản phẩm từ sữa. Đặc biệt, vitamin B12 có nhiều nhất trong các loại ngao và gan động vật. Ngoài ra, vitamin B12 cũng được thêm vào một số thực phẩm, chẳng hạn như ngũ cốc ăn sáng tăng cường và có sẵn dưới dạng thực phẩm bổ sung qua đường uống. Bác sĩ có thể kê đơn thuốc tiêm vitamin B12 hoặc thuốc uống để điều trị tình trạng thiếu vitamin B12.

Vitamin B12 có tác dụng gì? 9 công dụng nổi bật
Cải thiện tình trạng thiếu máu
Cơ thể người cần vitamin B12 để tạo ra các tế bào hồng cầu, bạch cầu và tiểu cầu khỏe mạnh. Mỗi ngày, khoảng 1% tế bào hồng cầu già nhất trong cơ thể bị phá hủy và thay thế. Các tế bào hồng cầu mới cần vitamin B12 và folate (vitamin B9) để phát triển và tăng trưởng. Nếu thiếu các vitamin này, việc tạo DNA sẽ trở nên khó khăn, khiến các tế bào hồng cầu chưa trưởng thành đã chết đi, từ đó dẫn đến tình trạng thiếu máu.

Hỗ trợ xương chắc khoẻ
Một số nghiên cứu đã chứng minh rằng vitamin B, trong đó bao gồm vitamin B12, có tác dụng giúp làm giảm nguy cơ loãng xương (một căn bệnh làm xương yếu đi) và gãy xương hông. Tuy nhiên, chưa có nghiên cứu nào kết luận rằng việc bổ sung vitamin B12 sẽ ngăn ngừa được các vấn đề về xương này.

Cải thiện thị lực
Một tình trạng hiếm gặp do thiếu vitamin B12 chính là bệnh thần kinh thị giác. Điều này có nghĩa là dây thần kinh thị giác (dây thần kinh truyền thông tin thị giác từ mắt đến não) bị tổn thương, dẫn đến mất thị lực dần dần và làm tăng nguy cơ nhìn thấy điểm mù.

Phòng ngừa và điều trị bệnh trầm cảm
Một số nghiên cứu còn cho thấy mối liên hệ giữa bệnh trầm cảm và hàm lượng vitamin B12 thấp trong cơ thể. Do đó, một trong những biện pháp hữu ích giúp ngăn ngừa sự khởi phát của bệnh trầm cảm chính là tiến hành sàng lọc trước những đối tượng có nguy cơ thiếu hụt vitamin B12 và bổ sung vitamin B12 sớm.

Tăng cường trí nhớ
Sự thiếu hụt vitamin B12 trong cơ thể còn có liên quan đến các vấn đề về nhận thức (các vấn đề về suy nghĩ, phán đoán và học tập) và các vấn đề về trí nhớ. Ngoài ra, những người có hàm lượng vitamin B12 thấp còn có thể tăng nguy cơ mắc bệnh Alzheimer và đột quỵ. Bên cạnh đó, nhiều nghiên cứu cho thấy việc cung cấp vitamin B12 cho những người có vấn đề về nhận thức nhẹ hầu hết đều giúp cải thiện các triệu chứng nhận thức đáng kể.

Bổ sung và tăng cường năng lượng cho cơ thể
Một số loại vitamin, bao gồm vitamin B12, có tác dụng chống lại tình trạng mệt mỏi và thiếu năng lượng của cơ thể. Đối với những người liên tục cảm thấy uể oải và có ngưỡng vitamin B12 thấp, việc bổ sung vitamin B12 với liều lượng hợp lý có thể giúp người đó có nhiều năng lượng hơn. Tuy nhiên, các thực phẩm bổ sung vitamin B12 hầu như không có tác dụng gì đối với những người đã có lượng vitamin B12 ở mức bình thường. Lúc này, bác sĩ có thể sẽ kê thêm các viên uống bổ sung vitamin B12 cho bạn.

Giúp da khoẻ đẹp
Khi lượng vitamin B12 trong cơ thể bị suy giảm, làn da có thể bị tăng sắc tố (các đốm đen) hoặc bạch biến (các mảng sáng) trên da kèm theo tình trạng loét miệng, chàm (eczema) và mụn trứng cá. Mặt khác, nếu có quá nhiều vitamin B12 trong cơ thể cũng có thể gây ra bạch biến, loét miệng, chàm và mụn trứng cá.

Giúp tóc chắc khoẻ
Nhiều nghiên cứu đã chứng minh rằng việc thiếu vitamin B12 có liên quan chặt chẽ đến tình trạng rụng tóc, nhưng hiện nay không có đủ bằng chứng cho thấy việc bổ sung vitamin B12 sẽ giúp kích thích tóc mọc lại. Mà vitamin B12 hỗ trợ giúp tóc chắc khoẻ, hạn chế tình trạng gãy rụng do cơ thể thiếu chất.

Hỗ trợ cải thiện tình trạng móng tay
Nếu cơ thể một người có quá ít vitamin B12, móng tay của người đó có thể chuyển sang màu nâu, xám hoặc xanh lam. Hiện tượng này sẽ cải thiện rõ rệt sau khi đã bổ sung đủ vitamin B12 lên.

Nguyên nhân gây thiếu hụt Vitamin B12
Một số nguyên nhân thiếu vitamin B12 thường gặp là thiếu máu ác tính, tình trạng tự miễn dịch và các rối loạn không do tình trạng miễn dịch ở dạ dày hoặc ruột non ngăn cản sự hấp thu vitamin B12.
- Thiếu máu ác tính: Thiếu máu ác tính là một nguyên nhân phổ biến gây thiếu vitamin B12 và thường xảy ra ở nữ giới hơn so với nam giới. Đây là một tình trạng tự miễn dịch làm ngăn cản sự hình thành phức hợp của yếu tố nội tại và vitamin B12, từ đó làm giảm sự hấp thụ vitamin này một cách đáng kể. Thiếu máu ác tính thường liên quan đến các tình trạng miễn dịch hoặc kháng thể tự miễn dịch khác như viêm teo dạ dày do kháng thể kháng tế bào thành, bệnh tuyến giáp tự miễn, suy tuyến thượng thận, đái tháo đường tuýp 1.
- Chế độ ăn uống không đầy đủ: Vitamin B12 chỉ có trong thực phẩm có nguồn gốc từ động vật. Do đó, những người ăn chay trường và một số phụ nữ mang thai hoặc đang cho con bú hạn chế protein động vật có thể bị thiếu vitamin này.
- Hấp thu kém vitamin B12 trong thức ăn: Hấp thu kém Vitamin B12 trong thức ăn là tình trạng thiếu hụt vitamin này mặc dù lượng vitamin B12 trong thức ăn ở mức bình thường. Nguyên nhân chính là do cơ thể không có khả năng giải phóng vitamin B12 từ thực phẩm. Do đó, những trường hợp này có thể hấp thụ các thực phẩm chức năng có chứa vitamin B12, nhưng ít có khả năng hấp thụ vitamin này trong thực phẩm.
- Phẫu thuật cắt dạ dày, phẫu thuật giảm cân hoặc viêm dạ dày: Phẫu thuật cắt dạ dày, phẫu thuật giảm cân và viêm dạ dày là những nguyên nhân tương đối phổ biến gây thiếu vitamin B12. Việc thiếu acid dạ dày và pepsin trong những tình trạng này dẫn đến việc giảm giải phóng vitamin B12 khỏi thực phẩm và giảm sản xuất yếu tố nội tại, do đó làm suy yếu sự hấp thụ vitamin này.
- Các thuốc/hoá chất làm giảm hấp thu Vitamin B12: Việc sử dụng lâu dài thuốc ức chế bơm proton, kháng acid và kháng thụ thể H2 đều làm giảm khả năng hấp thu vitamin B12 do giảm sự phân giải vitamin này khỏi thức ăn. Bên cạnh đó, người sử dụng thuốc Metformin trong một thời gian dài cũng dẫn đến sự mất cân bằng nội sinh liên quan đến Calci và giảm hấp thu vitamin B12.
- Suy tụy: Tuyến tuỵ sản xuất các enzyme cần thiết để phân giải vitamin B12 từ nước bọt và thức ăn, cho phép vitamin này liên kết với yếu tố nội tại. Do đó, người bệnh suy tụy hoặc mắc các bệnh liên quan đến tụy mạn tính có thể thiếu vitamin B12.
- Viêm ruột non hoặc phẫu thuật ruột non: Các rối loạn liên quan đến ruột non như sự phát triển quá mức của hệ vi khuẩn đường ruột, bệnh viêm ruột, viêm ruột do bức xạ, bệnh Celiac, ung thư hạch, viêm hồi tràng do lao, bệnh Amyloidosis hoặc cắt bỏ hồi tràng gây nên tình trạng giảm hấp thu vitamin B12.
- Nhiễm sán dải cá: Sán dải cá hấp thụ vitamin B12 ở hồi tràng dẫn đến thiếu vitamin này, nhiễm trùng có thể do ăn sống một số loại cá nước ngọt.
- Rối loạn di truyền liên quan đến vitamin B12: Trong một số ít trường hợp, thiếu vitamin B12 là do nguyên nhân đột biến gen lặn như hội chứng Imerslund-Gräsbeck; thiếu hụt cobalamin ở trẻ vị thành niên; hiện tượng đa hình trong gen mã hóa transcobalamin và chuyển hoá vitamin B12.
Dấu hiệu cơ thể thiếu hụt Vitamin B12
Những người đang bị thiếu hụt vitamin B12 trong cơ thể có thể nhận thấy các dấu hiệu bất thường sau đây:
- Mệt mỏi, suy nhược: Cảm giác mệt mỏi kéo dài dù ngủ đủ giấc.
- Thiếu máu: Da nhợt nhạt, lưỡi bị nóng rát.
- Tê bì tay chân: Cảm giác tê hoặc ngứa ran ở tay, chân.
- Rối loạn tiêu hóa: Chán ăn, đầy hơi, táo bón hoặc tiêu chảy.
- Suy giảm trí nhớ: Khó tập trung, trí nhớ kém.
- Căng thẳng thần kinh, trầm cảm: Tâm trạng thất thường, lo âu, dễ cáu gắt.

Những đối tượng có nguy cơ thiếu hụt Vitamin B12
Trên thực tế, có những đối tượng có nguy cơ thiếu hụt vitamin B12 cao hơn hẳn những người khác. Cụ thể bao gồm:
- Người già: Khả năng hấp thu kém đi theo tuổi tác.
- Người ăn chay trường: Thiếu thực phẩm giàu B12 từ động vật.
- Người bị bệnh về tiêu hóa: Ảnh hưởng đến khả năng hấp thụ B12.
- Người nghiện rượu: Rượu cản trở quá trình hấp thụ B12.
- Người dùng thuốc điều trị bệnh: Một số loại thuốc có thể làm giảm hấp thụ B12.

Một số tác dụng phụ của Vitamin B12
Mặc dù vitamin B12 là một dưỡng chất thiết yếu cho cơ thể và thường an toàn khi bổ sung, nhưng cũng có một số tác dụng phụ tiềm ẩn cần lưu ý, đặc biệt ở những người thực hiện tiêm bắp:
- Có thể gây chảy máu nếu đang dùng thuốc chống đông.
- Sốc phản vệ.
- Ngứa hoặc phát ban.
- Rối loạn tiêu hóa (ăn không ngon, buồn nôn, tiêu chảy…).
- Nhức đầu.
- Gây tê hay liệt yếu ở tay, chân, mặt.
- Ảnh hưởng trên tim mạch: tăng nhịp tim, khó thở, đau ngực, cao huyết áp, suy tim.
- Tăng cao gấp 3 lần nguy cơ ung thư tiền liệt tuyến.
- Gây tổn thương thần kinh thị giác cho người mắc bệnh Leber (bệnh thoái hóa sắc tố võng mạc bẩm sinh gây mù ở trẻ em).
- Phản ứng dị ứng: nổi mề đay, khó thở, sưng mặt, môi, lưỡi hoặc cổ họng.

Cách bổ sung Vitamin B12 hiệu quả
Bổ sung Vitamin B12 từ thực phẩm
Vitamin B12 có mặt trong các loại thực phẩm động vật như:
- Thịt: Thịt bò, thịt gà, thịt lợn, thịt cừu.
- Cá: Cá hồi, cá ngừ, cá thu, cá mòi.
- Trứng: Trứng gà, trứng vịt.
- Sữa và các sản phẩm từ sữa: Sữa bò, phô mai, sữa chua.
- Hải sản: Tôm, cua, nghêu, sò.
- Ngoài ra, bạn có thể tìm thấy Vitamin B12 trong các loại thực phẩm được bổ sung, như ngũ cốc ăn sáng, sữa đậu nành, sữa hạnh nhân.
Tuy nhiên, cần lưu ý rằng việc bổ sung vitamin B12 từ thực phẩm cần đúng cách, đúng hàm lượng, đúng thời điểm để đảm bảo đạt được hiệu quả cao nhất. Cụ thể như sau:
- Nên ăn các loại thực phẩm giàu Vitamin B12 một cách đa dạng và cân bằng để cung cấp đầy đủ dưỡng chất cho cơ thể.
- Nếu bạn là người ăn chay trường, bạn cần bổ sung Vitamin B12 từ các nguồn thực phẩm bổ sung hoặc thảo dược.
- Nên tham khảo ý kiến của bác sĩ để xác định nhu cầu Vitamin B12 phù hợp với cơ thể.

Sử dụng các sản phẩm bổ sung Vitamin B12
Ngoài việc bổ sung vitamin B12 từ các thực phẩm thông thường, mọi người có thể cân nhắc sử dụng thêm các sản phẩm bổ sung vitamin B12 với liều lượng hợp lý. Một số sản phẩm đang lưu hành rộng rãi trên thị trường bao gồm:
Vitabiotics Feroglobin B12 hỗ trợ tăng khả năng tạo máu (hộp 30 viên):
- Giá: 327.000 đồng/hộp.
- Thương hiệu: Vitabiotics (Anh).
- Thành phần chính (trong 1 viên): Sắt (dưới dạng Sắt (II) fumarat) 24mg, Kẽm (dưới dạng Kẽm sulfat) 12mg, Vitamin B6 (Pyridoxin hydroclorid) 5mg, Đồng (dưới dạng Đồng sulfat) 2mg, Folacin (Folic acid) 500mcg, Vitamin B12 (Cyanocobalamin) 10mcg.
- Công dụng: Giúp bổ sung sắt, acid folic và vitamin. Hỗ trợ tăng khả năng tạo máu, tăng cường sức khỏe, nâng cao sức đề kháng.
- Cách dùng – Liều dùng: Uống 1 viên/ngày, sau ăn. Uống với một cốc nước lạnh, không được nhai, không dùng quá liều khuyến cáo.
- Đối tượng sử dụng: Người thiếu máu do thiếu sắt từ 13 tuổi trở lên; Bà mẹ mang thai, cho con bú, vận động viên và những người giảm cân.

Siro Vitabiotics Feroglobin B12 Liquid hỗ trợ quá trình tạo máu (chai 200mL):
- Giá: 359.000 đồng/chai.
- Thương hiệu: Vitabiotics (Anh).
- Thành phần (mỗi 10mL): Malt 1000mg, Mật ong 200mg, L-lysine (Hydrochlorid) 40mg, Calci Glycerophosphate 20mg, Niacin (Nicotinamid) 20mg, Sắt (Sắt (III) Ammonium Citrate) 20mg, Vitamin B1 (Thiamin hydrochlorid) 10mg, Kẽm (Kẽm sulphate) 6mg, Pantothenic acid (D-Panthenol) 4mg, Vitamin B2 (Natri Riboflavin Phosphate) 2mg, Vitamin B6 (Pyridoxine hydrochloride) 2mg, Mangan (Mangan sulphate) 0,5mg, Đồng (Đồng sulphate) 0,4mg, Folacin (Folic acid) 100μg, Vitamin B12 (Cyanocobalamin) 10μg.
- Công dụng: Hỗ trợ tăng khả năng tạo máu, hỗ trợ tăng cường sức khỏe, hỗ trợ nâng cao sức đề kháng; Hỗ trợ bổ sung sắt, acid folic và các vitamin.
- Cách dùng – Liều dùng:
+ Trẻ từ 1 – 2 tuổi: 1/2 thìa (5mL) x 2 lần/ngày.
+ Trẻ từ 3 – 12 tuổi: 1 thìa (10mL) x 1 lần/ngày.
+ Trẻ từ 13 tuổi, người lớn: 1 thìa (10mL) x 1 lần/ngày.
+ Phụ nữ có thai, phụ nữ trong kỳ hành kinh, có thể dùng: 1 – 2 thìa x 2 lần/ngày.
- Đối tượng sử dụng: Người thiếu máu do thiếu sắt từ 1 tuổi trở lên và người lớn; bà mẹ mang thai, cho con bú, vận động viên và phụ nữ trong thời kỳ kinh nguyệt.

Vitamin 3B Gold PV hỗ trợ tăng đề kháng (hộp 100 viên):
- Giá: 42.500 đồng/hộp.
- Thương hiệu: Phúc Vinh (Việt Nam).
- Thành phần (mỗi viên): Vitamin B1 (Thiamin mononitrate) 10mg, Vitamin B6 (Pyridoxin hydrochlorid) 10mg, Vitamin B12 (Cyanocobalamin) 5,6 mcg; Gelatin, glycerin, lecithin, titan dioxyd, ponceau 4R, sorbitol, nipazil, nipazol, dầu nành vừa đủ 1 viên.
- Công dụng: Vitamin 3B Gold bổ sung vitamin B1, B6, B12 cho cơ thể, tăng cường sức khỏe, nâng cao sức đề kháng; Hỗ trợ giảm các triệu chứng tê bì chân tay, đau dây thần kinh ngoại biên do thiếu vitamin nhóm B.
- Cách dùng – Liều dùng:
+ Người lớn: Ngày uống 2 viên, mỗi lần uống 1 viên, uống vào buổi sáng và buổi trưa sau bữa ăn.
+ Trẻ em trên 2 tuổi: Ngày uống 1 viên, uống vào buổi sáng hoặc buổi trưa sau bữa ăn.
- Đối tượng sử dụng: Người thiếu vitamin nhóm B.

Cách dùng, liều dùng và một số tương tác thuốc khi bổ sung Vitamin B12
Cách dùng Vitamin B12
Vitamin B12 được dùng để điều trị tình trạng thiếu vitamin B12 ở dạng cyanocobalamin và Hydroxocobalamin. Thời gian điều trị thiếu vitamin này phụ thuộc vào nguyên nhân gây ra sự thiếu hụt. Việc bổ sung vitamin B12 suốt đời là cần thiết đối với những người có tình trạng không hồi phục (phẫu thuật cắt dạ dày). Nếu nguyên nhân của sự thiếu hụt có thể được điều trị hoặc loại bỏ (chế độ ăn kiêng quá mức, thiếu hụt do thuốc, nguyên nhân gây ra chứng kém hấp thu có thể đảo ngược), thì có thể ngừng bổ sung vitamin B12 sau khi sự thiếu hụt được khắc phục.
Liều dùng vitamin B12 đối với bệnh nhân thiếu vitamin này như sau:
- Người lớn: 1000 mcg uống một lần mỗi ngày.
- Trẻ em 6 tháng đến 18 tuổi: Uống 1000 mcg hàng ngày trong một tuần, tiếp theo là cách ngày trong một tuần, hai ngày một tuần trong hai tuần, và sau đó là hàng tuần trong ba tháng.
Vitamin B12 có thể được dùng đường tiêm như tiêm bắp, tiêm dưới da; đường ngậm dưới lưỡi và nhỏ mũi. Tùy vào mỗi trường hợp cụ thể mà cách dùng sẽ khác nhau:
- Đối với bệnh nhân có thiếu máu hồng cầu to có triệu chứng nghiêm trọng, bệnh nhân nên được bắt đầu điều trị bằng vitamin B12 đường tiêm sau đó chuyển sang đường uống khi hết triệu chứng.
- Đối với bệnh nhân kém hấp thu vitamin B12, thuốc nên được sử dụng đường tiêm thay cho đường uống để đảm bảo được sự dung nạp thuốc và tuân thủ điều trị.
- Đối với bệnh nhân thiếu vitamin B12 do thiếu hụt trong chế độ ăn, bệnh nhân cần bổ sung vitamin này bằng đường uống.
- Ngoài ra cũng có thể bổ sung vitamin B bằng Nat B trong bữa ăn một cách tiện lợi.
Một số lưu ý khi sử dụng thuốc hoặc các sản phẩm bổ sung vitamin B12 để đảm bảo đạt hiệu quả cao bao gồm:
- Không sử dụng nhiều dạng Cyanocobalamin khác nhau (dạng viên, dạng lỏng và các dạng khác) cùng một lúc, nếu không người dùng có thể bị quá liều.
- Thực hiện theo hướng dẫn cẩn thận về việc nên dùng Cyanocobalamin cùng hay không cùng với thức ăn.
- Nuốt toàn bộ viên thuốc giải phóng kéo dài và không nghiền nát, nhai hoặc bẻ viên thuốc.
- Đo thuốc lỏng, dung dịch Cyanocobalamin bằng dụng cụ đo đi kèm.
- Không nuốt viên ngậm, viên nén phân hủy hoặc viên ngậm dưới lưỡi, cần để thuốc tan từ từ trong miệng mà không cần nhai.
- Viên ngậm dưới lưỡi hoặc chất lỏng phải được đặt dưới lưỡi.
- Nếu cần phẫu thuật, hãy báo cáo với bác sĩ phẫu thuật trước nếu đang sử dụng Cyanocobalamin vì có thể cần phải ngừng sử dụng Cyanocobalamin trong một thời gian ngắn trước khi phẫu thuật.
- Cyanocobalamin có thể ảnh hưởng đến kết quả của một số xét nghiệm trong phòng thí nghiệm. Hãy báo cáo với bác sĩ trước khi cần thực hiện bất kỳ xét nghiệm nào trong thời gian sử dụng Cyanocobalamin.
- Liều lượng Cyanocobalamin khuyến cáo hàng ngày thay đổi theo độ tuổi, vì vậy cần tham khảo ý kiến bác sĩ trước khi sử dụng để đảm bảo không bị quá liều.
- Liên hệ ngay với bác sĩ nếu tình trạng bệnh đang điều trị bằng Cyanocobalamin không cải thiện hoặc trở nên trầm trọng hơn khi sử dụng sản phẩm này.

Liều dùng khi bổ sung Vitamin B12
Liều dùng vitamin B12 thông thường cho người lớn mắc bệnh thiếu máu ác tính:
- Liều khởi đầu: 100 mcg tiêm bắp hoặc tiêm dưới da sâu, 1 lần/ngày, trong 6 đến 7 ngày.
Nếu thấy có cải thiện trên lâm sàng và đáp ứng của hồng cầu lưới từ liều dùng trên, tiến hành giảm liều như sau:
100 mcg cách ngày trong 7 liều, sau đó:
100 mcg cứ 3 đến 4 ngày trong 2 đến 3 tuần. - Liều duy trì: 100 đến 1000 mcg hàng tháng.
- Thời gian điều trị: Suốt đời.
Liều dùng vitamin B12 thông thường cho người lớn bị thiếu hụt dinh dưỡng B12: 25 đến 2000 mcg/ngày.
Liều dùng vitamin B12 thông thường cho người lớn để thử nghiệm Schilling: 1000 mcg/lần tiêm bắp.
Liều dùng vitamin B12 thông thường cho trẻ em bị thiếu hụt dinh dưỡng B12: 0,5 đến 3 mcg/ngày.
Một số tương tác thuốc với Vitamin B12
Vitamin B12 khi vào cơ thể có thể xuất hiện tương tác làm thay đổi hoạt tính của một số thuốc điều trị bệnh khác. Vì thế người dùng nên trao đổi với bác sĩ về việc dùng vitamin B12 nếu đang dùng các thuốc sau:
- Thuốc Metformin điều trị đái tháo đường.
- Thuốc điều trị viêm loét dạ dày như thuốc chẹn H2 (Ranitidine, Cimetidin…) và thuốc ức chế bơm proton PPI (Omeprazol, Pantoprazol…).
- Thuốc kháng sinh gồm Neomycin và Chloramphenicol.
- Thuốc tránh thai đường uống.
- Vitamin C.
- Thuốc điều trị bênh tiêu hóa.
- Acid folic.
- Thuốc bổ sung Kali.

Đối tượng không nên bổ sung Vitamin B12
Không nên dùng thực phẩm bổ sung vitamin B12 nếu bạn nhạy cảm hoặc dị ứng với vitamin B12, Coban hoặc bất kỳ thành phần nào khác. Không nên dùng vitamin B12 cho bệnh nhân ung thư, vì chúng có thể làm tăng tốc độ phát triển của các tế bào ác tính dẫn đến ung thư phát triển nhanh hơn. Ngoài ra, vitamin B12 còn không được dùng cho người mắc bệnh trứng cá, người có tiền sử dị ứng thuốc, bệnh nhân suy thận hoặc bị thiếu máu chưa rõ nguyên nhân.
Một số lưu ý khi bổ sung Vitamin B12 hiệu quả
Vitamin B12 là một loại vitamin tan trong nước, vì thế để cơ thể hấp thụ tốt nhất thì người dùng nên uống vitamin B12 vào những thời điểm sau:
- Uống khi đói bụng.
- Uống trước khi ăn sáng 30 phút.
Tùy thuộc vào chế độ dinh dưỡng và mức độ thiếu hụt vitamin B12 trong máu mà bác sĩ sẽ chỉ định uống bổ sung vitamin B12 trong các khoảng thời gian khác nhau:
- Bạn có thể ngừng uống vitamin B12 khi nồng độ vitamin này trong máu đạt mức bình thường và ổn định.
- Nếu bạn ăn chay trường, cho con bú hoặc ăn quá ít thực phẩm chứa vitamin B12 thì có thể phải uống bổ sung vitamin B12 trong thời gian dài hơn.

Khi nào cần gặp bác sĩ?
Các dấu hiệu bất thường
Những người đang sử dụng thuốc hoặc sản phẩm bổ sung vitamin B12 cần liên hệ ngay với bác sĩ nếu phát hiện thấy những dấu hiệu bất thường sau:
- Sốc phản vệ.
- Tê hay liệt yếu ở tay, chân.
- Tăng nhịp tim, khó thở, đau ngực, cao huyết áp, suy tim.
- Tăng cao gấp 3 lần nguy cơ ung thư tiền liệt tuyến.
- Suy giảm thị lực.
- Nổi mề đay, khó thở, sưng mặt, môi, lưỡi hoặc cổ họng.

Một số bệnh viện, chuyên khoa dinh dưỡng uy tín
Nếu cảm thấy cơ thể đang có các dấu hiệu bị thiếu hụt vitamin B12, bạn đọc nên đến các bệnh viện, chuyên khoa dinh dưỡng uy tín để được xét nghiệm và chẩn đoán chính xác hơn, đồng thời các bác sĩ sẽ tư vấn cho bạn phác đồ điều trị hợp lý:
- DiaB – Giải Pháp Toàn Diện Cho Người Đái Tháo Đường
- Viện Nghiên cứu và tư vấn Dinh dưỡng NRECI
- Viện dinh dưỡng quốc gia
- Bệnh viện Quốc tế City – City International Hospital (CIH)
- Viện Dinh Dưỡng Quốc Gia Cơ sở 2
Một số câu hỏi liên quan
Nên bổ sung Vitamin B12 lúc nào là tốt nhất?
Đối với người có chế độ ăn đa dạng các nhóm thức ăn thì không cần bổ sung vitamin B12. Vitamin này chỉ cần bổ sung trong các trường hợp thiếu hụt và có triệu chứng nghiêm trọng. Khi cần thiết, vitamin B12 thường được uống một lần mỗi ngày, vào buổi sáng lúc bụng đang đói, trước ăn 30 phút để cơ thể hấp thu hiệu quả nhất.
Thiếu Vitamin B12 gây bệnh gì?
Sự thiếu hụt vitamin B12 gây ra thiếu máu hồng cầu khổng lồ, tổn thương chất trắng của tủy sống và não, và bệnh thần kinh ngoại vi. Tình trạng thiếu vitamin B12 thường được chẩn đoán bằng cách đo mức vitamin B12 huyết thanh. Bên cạnh đó, thử nghiệm Schilling giúp xác định nguyên nhân thiếu vitamin B12 trong cơ thể.
Tiêm Vitamin B12 có tác dụng gì?
Vitamin B12 đóng vai trò thiết yếu trong quá trình hình thành tế bào hồng cầu, tham gia vào quá trình chuyển hóa tế bào, bảo vệ chức năng hệ thần kinh trung ương (bao gồm não và tủy sống) và làm nhiệm vụ sản xuất DNA, RNA, các phân tử bên trong tế bào mang thông tin di truyền. Bên cạnh đó, vitamin B12 còn giúp giữ cho tóc, móng và da của con người khỏe mạnh. Vì vậy, tiêm vitamin B12 cho những người đang thiếu hụt loại vitamin này sẽ giúp phòng ngừa các bệnh lý liên quan.
Vitamin B12 có tác dụng gì cho da?
Thiếu vitamin B12 có thể gây tăng sắc tố da, cải thiện tóc và móng tay. Ngoài ra, một số tình trạng da liễu, bao gồm bệnh bạch biến, viêm miệng áp xe, viêm da dị ứng và mụn trứng cá đều có liên quan đến tình trạng dư thừa hoặc thiếu hụt vitamin này.
Vitamin B12 có trong các loại thực phẩm gì?
Vitamin B12 có nhiều trong những thực phẩm nguồn gốc động vật như gia cầm, thịt, cá và các sản phẩm từ sữa. Ngoài ra, vitamin B12 cũng được thêm vào một số thực phẩm, chẳng hạn như ngũ cốc ăn sáng tăng cường và có sẵn dưới dạng thực phẩm bổ sung qua đường uống. Bác sĩ có thể kê đơn thuốc tiêm vitamin B12 hoặc thuốc xịt mũi để điều trị tình trạng thiếu vitamin B12.
Xem thêm:
- Top 5 cặp vitamin và khoáng chất không nên dùng cùng nhau!
- 7 dấu hiệu nhận biết cơ thể thiếu vitamin cần bổ sung ngay!
- Vitamin B7 – Top 7 lợi ích đối với sức khỏe của mọi người
Hy vọng rằng thông qua bài viết này, bạn đọc đã có cái nhìn rõ hơn về vitamin B12 và các bệnh lý có thể xảy ra do thiếu vitamin B12. Nếu cảm thấy bài viết hữu ích, hãy chia sẻ rộng rãi đến người thân và bạn bè để mọi người đều biết cách phòng tránh tình trạng thiếu hụt vitamin B12.
Mời bạn tham khảo Gói xét nghiệm vi chất có tại Docosan
Nguồn tham khảo:
1. Vitamin B-12
- Link tham khảo: https://www.mayoclinic.org/drugs-supplements-vitamin-b12/art-20363663
- Ngày tham khảo: 03/09/2024
2. Vitamin B12: What to Know
- Link tham khảo: https://www.webmd.com/diet/vitamin-b12-deficiency-symptoms-causes
- Ngày tham khảo: 03/09/2024
3. Cyanocobalamin
- Link tham khảo: https://www.drugs.com/mtm/cyanocobalamin.html
- Ngày tham khảo: 03/09/2024
4. Vitamin B12 Deficiency
- Link tham khảo: https://www.msdmanuals.com/home/disorders-of-nutrition/vitamins/vitamin-b12-deficiency
- Ngày tham khảo: 03/09/2024
5. Vitamin B12 or folate deficiency anaemia
- Link tham khảo: https://www.nhs.uk/conditions/vitamin-b12-or-folate-deficiency-anaemia/symptoms/
- Ngày tham khảo: 03/09/2024




![Tác dụng và bổ sung vitamin B cho người bệnh thần kinh 25 [NATB] TÁC DỤNG VÀ BỔ SUNG VITAMIN B CHO NGƯỜI BỆNH THẦN KINH](https://www.docosan.com/blog/wp-content/uploads/2024/12/bo-sung-vitamin-b-cho-nguoi-benh-than-kinh-thumbnai-1-300x157.png)






